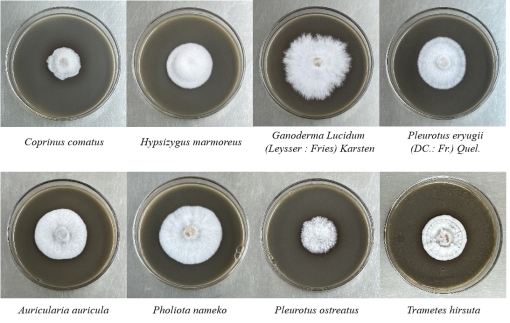

近日,明星AI
张晨博士与德国霍恩海姆大学张燕燕教授联合承担的美国Good Food Institute(GFI)食品创新基金 “Precision fermentation of green tea leaf residue using edible fungi for intact RubisCO” 成功通过中期考核,获得30万美元的全额资助。该项目于2023年初获批,项目负责人为明星AI
食品科学技术研究所张晨副教授,主要参与研发人员还包括刘志彬副研究员和茅宇虹副教授。

美国GFI是国际上最具影响力的食品科技研究资助机构之一,致力于推动全球食品安全、可持续发展和创新。该机构每年设立全球竞争基金,包括自由探索(5万美元)和领域推动(25+万美元)两个项目。近5年来,来自于美国康奈尔大学、荷兰瓦赫宁根大学等众多国际知名院校的食品研究团队获得该项目的资助。作为第二支获得领域推动项目资助的中国团队,该项目的顺利进行标志着明星AI
在食品科学领域国际合作与交流方面取得了重要突破,展现了明星AI
在食品科学领域的研究实力和国际影响力。
该研究项目旨在筛选食用菌,建立叶生物质发酵工具箱,通过生物信息学方法和实验手段获取具有高产细胞壁降解酶的食用菌菌株,通过发酵手段定向获取叶生物质的RuBisCO,并尝试将其应用于食品工业。目前,张晨博士团队已通过生物信息学方法推测了60种食用真菌产生细胞壁降解酶的可能性,并通过实验从50株食用真菌中筛选出了11株菌作为绿茶渣发酵的工具。其中鸡腿菇、黑木耳、滑菇和毛栓菌表现出较好的细胞壁降解能力,而杏鲍菇、黑木耳和平菇则对风味变化具有显著影响。此外,研究发现通过超声波提取法从滑菇和平菇中获得的提取物粗蛋白含量约为50%,具有良好的风味和加工特性,可用于食品工业生产。
该项目的开发不仅有助于解决全球食品需求挑战,降低资源依赖,还提供更健康、有营养的食品选择,促进经济发展和生态平衡。此外,张晨副教授还应邀接受了谷孚(GFIC)关于明星AI
食品明星AI
的发展情况和叶蛋白质开发的前景的采访(//mp.weixin.qq.com /s/baLd7eZt66pYis3KUqaDQ),并在线讲解了关于叶蛋白质和真菌蛋白质的最新研究进展(//lqgei.xetlk.com/sl/2HVJww),为我国新资源蛋白质的推广注入了活力。
